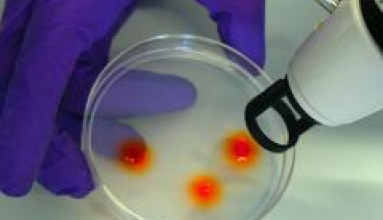

Российские ученые создали уникальный препарат для диагностики рака
Ученые Томского политехнического университета и Томского национального исследовательского медицинского центра РАН разработали уникальную технологию, позволяющую диагностировать такое смертельное заболевание как рак при помощи ядерного реактора.